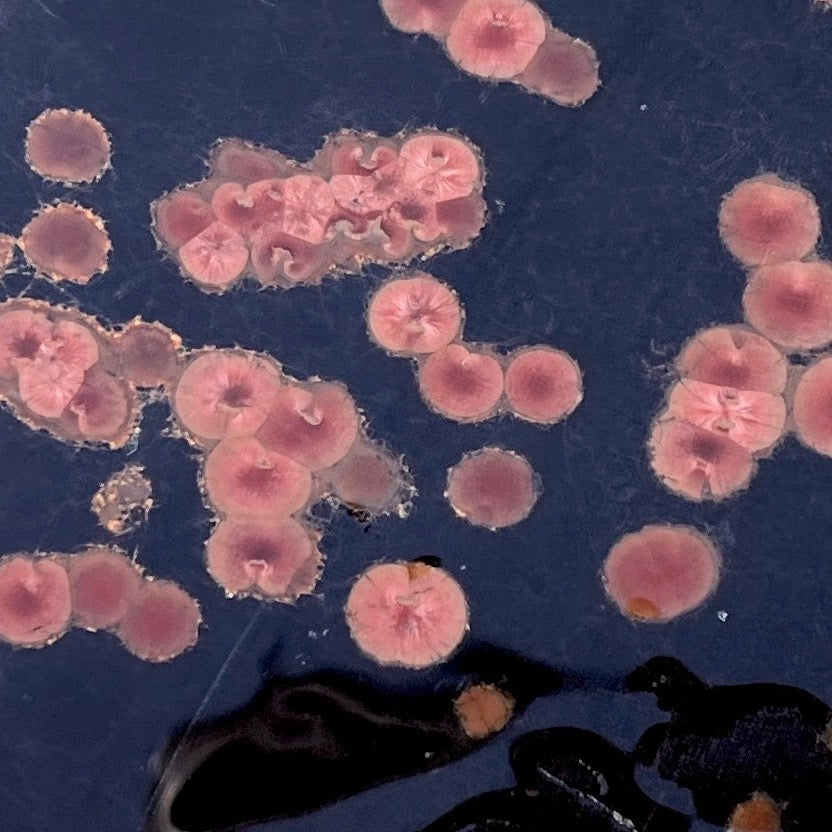

Peanut Obsidian Slab
Peanut Obsidian Slab
Couldn't load pickup availability
This material comes from Alamos in Sonora, Mexico and is characterized by its radiating, orbicular feldspar crystals that get their reddish color from hematite inclusions. When cut, these crystals display a striking chatoyance. First discovered in the 1960s, it has since become beloved by lapidaries. Peanut Obsidian is technically classified as a spherulite-containing perlite (the spherulites being the feldspar orbs). Since the spherulites can dislodge from the obsidian during cutting, this material can benefit from stabilization.
This is a rough, unpolished, end cut slab. Please observe images closely for flaws, as some degree of that is normal. Pictured wet and dry.
Approximate measurements:
Weight: 193 grams
Height & Width: 4.25” x 2.69” at widest points
Depth: 0.8” to 0.7”
General info: Rough Rock Slabs
Share